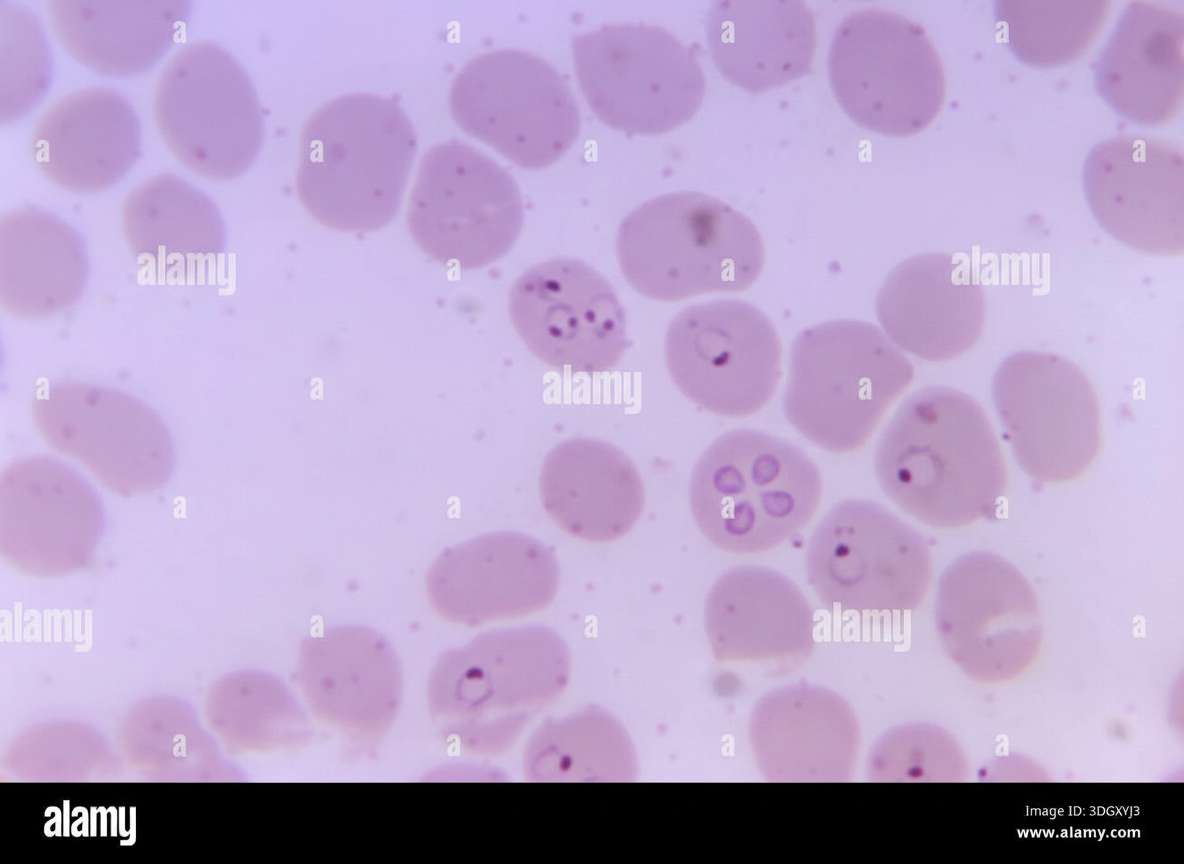
Image for question 36

A 64-year-old man is brought to the emergency department because of fever, chills, shortness of breath, chest pain, and a productive cough with bloody sputum for the past several days. He has metastatic pancreatic cancer and is currently undergoing polychemotherapy. His temperature is 38.3°C (101°F). Pulmonary examination shows scattered inspiratory crackles in all lung fields. A CT scan of the chest shows multiple nodules, cavities, and patchy areas of consolidation. A photomicrograph of a specimen obtained on pulmonary biopsy is shown. Which of the following is the most likely causal pathogen?

A 17-year-old girl comes to the physician because of a 1-week history of severe itching in the area of her genitals. She reports that the itching is most severe at night. She has been sexually active with three partners over the past year; she uses condoms for contraception. Her current sexual partner is experiencing similar symptoms. Pelvic examination shows vulvar excoriations. A photomicrograph of an epilated pubic hair is shown. Which of the following is the most likely causal organism?

A 28-year-old homeless male with a past medical history significant for asthma comes to your clinic complaining of a chronic rash on his scalp and feet. He describes the rash as “dry and flaky,” and reports it has been present for at least a year. He was using a new dandruff shampoo he got over the counter, with little improvement. The patient reports it is extremely itchy at night, to the point that he can't sleep. On exam, you note a scaly patch of alopecia, enlarged lymph glands along the posterior aspect of his neck, and fine scaling in between his toes and on the heel and sides of his foot. His temperature is 99°F (37°C), blood pressure is 118/78 mmHg, and pulse is 81/min. Which of the following is the most accurate test for the suspected diagnosis?
A 32-year-old woman presents to your office with abdominal pain and bloating over the last month. She also complains of intermittent, copious, non-bloody diarrhea over the same time. Last month, she had a cough that has since improved but has not completely resolved. She has no sick contacts and has not left the country recently. She denies any myalgias, itching, or rashes. Physical and laboratory evaluations are unremarkable. Examination of her stool reveals the causative organism. This organism is most likely transmitted to the human host through which of the following routes?
A 45-year-old woman presents to the emergency department with a headache, fevers with chills, rigors, and generalized joint pain for the past week. She also complains of a progressive rash on her left arm. She says that a few days ago she noticed a small, slightly raised lesion resembling an insect bite mark, which had a burning sensation. The medical and surgical histories are unremarkable. She recalls walking in the woods 2 weeks prior to the onset of symptoms, but does not recall finding a tick on her body. On examination, the temperature is 40.2°C (104.4°F). A circular red rash measuring 10 cm x 5 cm in diameter is noted on the left arm, as shown in the accompanying image. The remainder of her physical examination is unremarkable. The tick causing her disease is also responsible for the transmission of which of the following pathogens?

A 14-year-old boy presents to his pediatrician with weakness and frequent episodes of dizziness. He had chronic mucocutaneous candidiasis when he was 4 years old and was diagnosed with autoimmune hypoparathyroidism at age 8. On physical examination, his blood pressure is 118/70 mm Hg in the supine position and 96/64 mm Hg in the upright position. Hyperpigmentation is present over many areas of his body, most prominently over the extensor surfaces, elbows, and knuckles. His laboratory evaluation suggests the presence of antibodies to 21-hydroxylase and a mutation in the AIRE (autoimmune regulator) gene. The pediatrician explains to his parents that his condition is due to the failure of immunological tolerance. Which of the following mechanisms is most likely to have failed in the child?
An otherwise healthy 39-year-old woman presents to her primary care provider because of right-leg swelling, which started 4 months ago following travel to Kenya. The swelling has been slowly progressive and interferes with daily tasks. She denies smoking or alcohol use. Family history is irrelevant. Vital signs include: temperature 38.1°C (100.5°F), blood pressure 115/72 mm Hg, and pulse 99/min. Physical examination reveals non-pitting edema of the entire right leg. The overlying skin is rough, thick and indurated. The left leg is normal in size and shape. Which of the following is the most likely cause of this patient condition?
A 78-year-old woman living in New Jersey is brought to the emergency department in July with a fever for 5 days. Lethargy is present. She has had bloody urine over the last 48 hours but denies any nausea, vomiting, or abdominal pain. She has no history of serious illness and takes no medications. She has not traveled anywhere outside her city for the past several years. She appears ill. The temperature is 40.8℃ (105.4℉), the pulse is 108/min, the respiration rate is 20/min, and the blood pressure is 105/50 mm Hg. The abdominal exam reveals hepatosplenomegaly. Lymphadenopathy is absent. Petechiae are seen on the lower extremities. Laboratory studies show the following: Laboratory test Hemoglobin 8 g/dL Mean corpuscular volume (MCV) 98 µm3 Leukocyte count 4,200/mm3 Segmented neutrophils 32% Lymphocytes 58% Platelet count 108,000/mm3 Bilirubin, total 5.0 mg/dL Direct 0.7 mg/dL Aspartate aminotransferase (AST) 51 U/L Alanine aminotransferase (ALT) 56 U/L Alkaline phosphatase 180 U/L Lactate dehydrogenase (LDH) 640 U/L (N = 140–280 U/L) Haptoglobin 20 mg/dL (N = 30–200 mg/dL) Urine Hemoglobin + Urobilinogen + Protein + A peripheral blood smear is shown (see image). Which of the following is the most likely diagnosis?
A 26-year-old man is undergoing a bone marrow transplantation for treatment of a non-Hodgkin lymphoma that has been refractory to several rounds of chemotherapy and radiation over the past 2 years. He has been undergoing a regimen of cyclophosphamide and total body irradiation for the past several weeks in anticipation of his future transplant. This morning, he reports developing a productive cough and is concerned because he noted some blood in his sputum this morning. The patient also reports pain with inspiration. His temperature is 101°F (38.3°C), blood pressure is 115/74 mmHg, pulse is 120/min, respirations are 19/min, and oxygen saturation is 98% on room air. A chest radiograph and CT are obtained and shown in Figures A and B respectively. Which of the following is the most likely diagnosis?

A 3-month-old male is brought to the emergency room by his mother who reports that the child has a fever. The child was born at 39 weeks of gestation and is at the 15th and 10th percentiles for height and weight, respectively. The child has a history of eczema. Physical examination reveals an erythematous fluctuant mass on the patient's inner thigh. His temperature is 101.1°F (38.4°C), blood pressure is 125/70 mmHg, pulse is 120/min, and respirations are 22/min. The mass is drained and the child is started on broad-spectrum antibiotics until the culture returns. The physician also orders a flow cytometry reduction of dihydrorhodamine, which is found to be abnormal. This patient is at increased risk of infections with which of the following organisms?
Candida species
Practice Questions
Aspergillus species
Practice Questions
Cryptococcus neoformans/gattii
Practice Questions
Pneumocystis jirovecii
Practice Questions
Mucormycoses
Practice Questions
Dermatophytes
Practice Questions
Antifungal agents
Practice Questions
Opportunistic fungal infections
Practice Questions
Parasitic life cycles
Practice Questions
Soil-transmitted helminths
Practice Questions
Filarial nematodes
Practice Questions
Schistosomiasis
Practice Questions
Echinococci and other tissue helminths
Practice Questions
Get full access to all questions, explanations, and performance tracking.
Scan to download app
Enter your email to get your 85% OFF code and unlock the full USMLE question bank on the app.